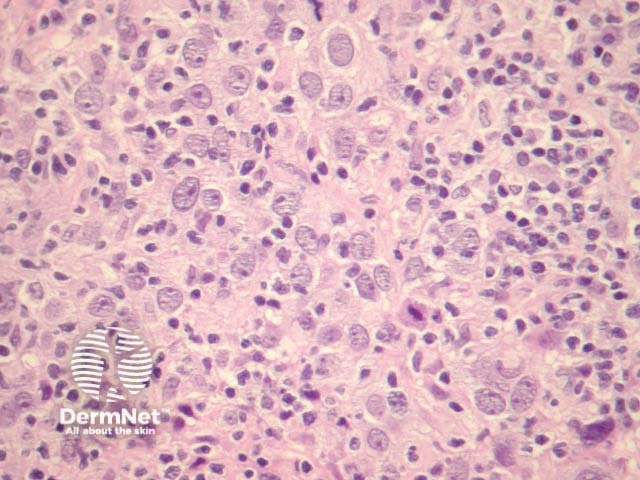
Figure 3

Main menu
Common skin conditions
NEWS
Join DermNet PRO
Read more
Quick links
Lesions (cancerous) Diagnosis and testing
Author: Assoc Prof Patrick Emanuel, Dermatopathologist, Auckland, New Zealand. January 2015.
Lymphoepithelioma-like carcinoma of the skin (LELCS) is a very rare primary skin neoplasm that typically occurs on the sun-exposed skin of the head and neck in elderly individuals. The histogenesis of LELCS remains controversial as to whether it has adnexal origin or represents an inflamed squamous cell carcinoma (SCC).
In lymphoepithelioma-like carcinoma, sections show atypical epithelioid cells forming well-defined nests surrounded by dense lymphocytic inflammation. High-power view shows a poorly differentiated carcinoma with lymphocytic infiltration (figures 1-3). Perineural, lymphovascular and subcutaneous invasion is common.

Figure 1

Figure 2
Figure 3
Immunohistochemical studies in lymphoepithelioma-like carcinoma reveal keratin positivity in the epithelioid cells. Markers to rule out lymphoid (LCA), melanocytic (S100), and neuroendocrine (CD56, synaptophysin, chromogranin) may be needed. Epstein–Barr virus-encoded small RNA (EBER) in situ hybridisation for Epstein-Barr virus (EBV) infection may be useful to rule out metastasis from a nasopharyngeal lymphoepithelioma.
Inflamed squamous cell carcinoma (SCC) — There is debate whether lymphoepithelioma-like carcinoma is just inflamed SCC. Overlying actinic dysplasia and clear squamous differentiation would favour SCC.
Lymphoepithelioma metastatic to the skin — “Lymphoepithelioma” is a primary tumour of the nasopharynx. Epstein-Barr virus is usually integrated in these nasopharyngeal tumours and this can be performed using in situ hybridisation.